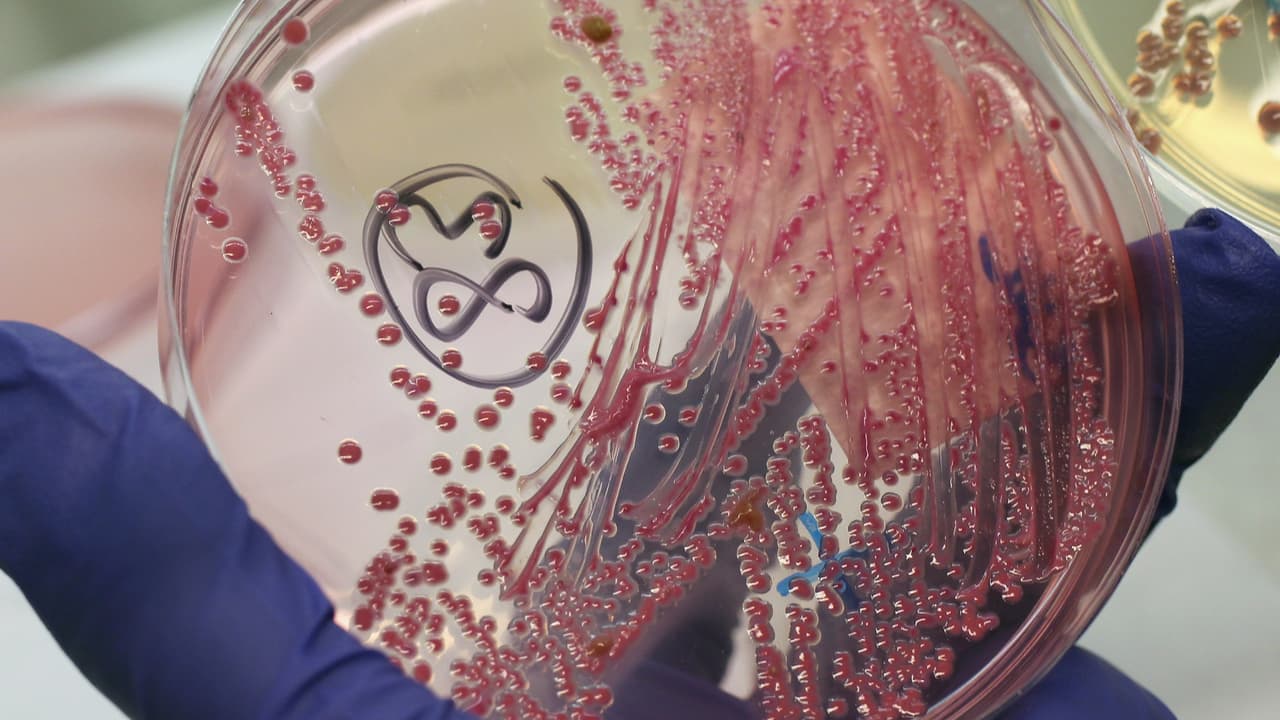

La mayoría de los niños que sufren leucodistrofia metacromática (MDL, por sus siglas en inglés) solo viven hasta los 7 años. Eso podría cambiar tras el anuncio de un nuevo tratamiento para tratar su enfermedad. Sin embargo, cuesta $4.5 millones.
Esta rara enfermedad mata a los niños antes de los 7 años. Su cura cuesta $4.5 millones: es el medicamento más caro del mundo
El tratamiento consiste en una sola infusión, individualizada y elaborada a partir de células madre hematopoyéticas (de la sangre) del propio paciente.
Se trata de Lenmeldy, un tratamiento genético que obtuvo esta semana la aprobación de la Administración de Drogas y Alimentos (FDA, por sus siglas en inglés). Es una terapia que podrá ser utilizada en personas con MDL infantil presintomática, juvenil temprana presintomática o juvenil temprana sintomática, explicó la FDA en un comunicado.
El tratamiento consiste en una sola infusión, individualizada y elaborada a partir de células madre hematopoyéticas (de la sangre) del propio paciente.
Notas Relacionadas
De acuerdo con Orchad Therapeutics, que es el laboratorio que produce la medicina, su costo total será de $4.5 millones para un tratamiento de una sola dosis, “lo que refleja su valor clínico, económico y social”, dice la empresa en un comunicado.
Solo cinco centros de tratamiento especializados estarán habilitados en todo EEUU para administrar el medicamento.
La empresa busca “reducir al mínimo la carga que suponen los desplazamientos para los pacientes que reúnen los requisitos”.
El laboratorio dijo que el tratamiento “se está ofreciendo a las aseguradoras privadas y públicas con acuerdos innovadores basados en los resultados para garantizar un acceso a un reembolso”.
¿Qué es el trastorno leucodistrofia metacromática?
De acuerdo con la FDA, el MDL es una enfermedad genética rara y debilitante que afecta al cerebro y al sistema nervioso.
Se desarrolla debido a una deficiencia de una enzima llamada arilsulfatasa A (ARSA), que provoca una acumulación de sulfátidos (sustancias grasas) en las células.
Esta acumulación provoca daños en el sistema nervioso central y periférico, que se manifiestan con pérdida de la función motora y cognitiva y muerte prematura.
Notas Relacionadas
En la forma más grave de MDL, los bebés se desarrollan con normalidad, pero al final de la infancia empiezan a perder rápidamente la capacidad de andar, hablar e interactuar con el mundo que les rodea.
“Estos niños acaban deteriorándose hasta llegar a un estado vegetativo, que puede requerir cuidados intensivos las 24 horas del día, y la mayoría fallece en los cinco años siguientes a la aparición de los síntomas, lo que supone una enorme carga emocional y económica para la familia”, explica el laboratorio.
Se calcula que el MDL afecta a una de cada 40,000 personas en Estados Unidos, dice la FDA. De acuerdo con Orchad Therapeutics, menos de 40 niños presentan este trastorno al año.
Hasta este nuevo tratamiento no existía cura para el MDL. El tratamiento suele centrarse en cuidados de apoyo y control de los síntomas.
"Se trata de la primera opción de tratamiento aprobada por la FDA para los niños que padecen esta rara enfermedad genética", dijo Peter Marks, director del Centro de Evaluación e Investigación Biológica de la FDA.
¿Cómo funciona el nuevo tratamiento para el MDL?
Lenmeldy es una infusión individualizada y de una sola dosis, elaborada a partir de células madre hematopoyéticas (de la sangre) del propio paciente, que han sido modificadas genéticamente para incluir copias funcionales del gen ARSA.
Las células madre modificadas se trasplantan al paciente, donde se injertan, se adhieren y multiplican en la médula ósea.
Notas Relacionadas
Las células madre modificadas aportan al organismo células mieloides (inmunitarias) que producen la enzima ARSA, que ayuda a descomponer la acumulación nociva de sulfátidos y puede detener la progresión del MDL.
Antes del tratamiento, los pacientes deben someterse a altas dosis de quimioterapia, un proceso que elimina células de la médula ósea para que puedan ser sustituidas por las células modificadas de Lenmeldy.
¿Qué resultados mostraron los ensayos clínicos con la nueva cura?
De acuerdo con la FDA, la seguridad y eficacia de Lenmeldy se evaluó a partir de los datos de 37 niños que recibieron el tratamiento en dos ensayos clínicos abiertos.
Los niños que recibieron tratamiento con Lenmeldy fueron comparados con niños no tratados.
Usualmente los niños que padecen MDL sufren de pérdida de locomoción y pérdida de capacidad para sentarse sin apoyo. Los ensayos evaluaron la eficacia en niños que no presentaron una discapacidad motora grave.
“En los niños con MLD, el tratamiento con Lenmeldy redujo significativamente el riesgo de deterioro motor grave o muerte en comparación con los niños no tratados”, dice el comunicado de la FDA.
Otro factor importante fue la supervivencia. Usualmente los niños con MDL no logran vivir más allá de los siete años, debido al deterioro constante de su salud.
“Todos los niños con MLD infantil tardía presintomática que fueron tratados con Lenmeldy estaban vivos a los 6 años de edad, en comparación con solo el 58% de los niños del otro grupo”, dice el documento.
Otro resultado importante del nuevo tratamiento fue que, a los cinco años, el 71% de los niños tratados eran capaces de caminar sin ayuda.
“El 85% de los niños tratados tenían puntuaciones normales en el coeficiente intelectual de lenguaje y rendimiento, lo que no se ha observado en niños no tratados”, concluye la FDA.
Los efectos secundarios más frecuentes de Lenmeldy son fiebre y recuento bajo de glóbulos blancos, llagas en la boca, infecciones respiratorias, erupción cutánea, infecciones de la vía médica, infecciones víricas, fiebre, infecciones gastrointestinales y aumento del tamaño del hígado, dice el laboratorio.
Orchard Assist indicó en un comunicado que ofrecerá apoyo individualizado a los pacientes elegibles y a sus cuidadores que se inscriban en el programa a lo largo del proceso de tratamiento.
Mira también: